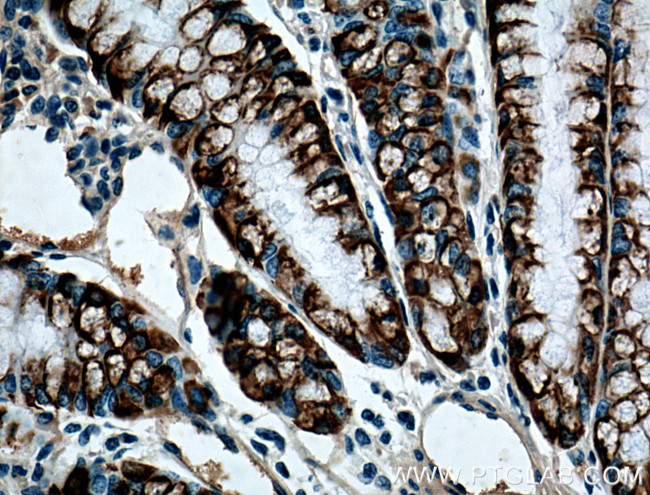
ST6GALNAC6 Antibody in Immunohistochemistry (Paraffin) (IHC (P))
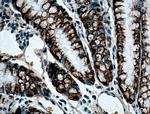
ST6GALNAC6 Antibody in Immunohistochemistry (Paraffin) (IHC (P))

Search
Proteintech
ST6GALNAC6 Monoclonal Antibody (1A7B7)
{{$productOrderCtrl.translations['antibody.pdp.commerceCard.promotion.promotions']}}
{{$productOrderCtrl.translations['antibody.pdp.commerceCard.promotion.viewpromo']}}
{{$productOrderCtrl.translations['antibody.pdp.commerceCard.promotion.promocode']}}: {{promo.promoCode}} {{promo.promoTitle}} {{promo.promoDescription}}. {{$productOrderCtrl.translations['antibody.pdp.commerceCard.promotion.learnmore']}}
产品信息
66209-1-IG
种属反应
宿主/亚型
分类
类型
克隆号
抗原
偶联物
形式
浓度
规格
纯化类型
保存液
内含物
保存条件
运输条件
产品详细信息
Immunogen sequence: VFHYGSLRG RSRRPVNLKK WSITDGYVPI LGNKTLPSRC HQCVIVSSSS HLLGTKLGPE IERAECTIRM NDAPTTGYSA DVGNKTTYRV VAHSSVFRVL RRPQEFVNRT PETVFIFWGP PSKMQKPQGS LVRVIQRAGL VFPNMEAYAV SPGRMRQFDD LFRGETGKDR EKSHSWLSTG WFTMVIAVEL CDHVHVYGMV PPNYCSQRPR LQRMPYHYYE PKGPDECVTY IQNEHSRKGN HHRFITEKRV FSSWAQLYGI TFSHPSWT (67-333 aa encoded by BC007802 )
靶标信息
ST6GALNAC6 belongs to a family of sialyltransferases that modify proteins and ceramides on the cell surface to alter cell-cell or cell-extracellular matrix interactions.
仅用于科研。不用于诊断过程。未经明确授权不得转售。
篇参考文献 (0)
生物信息学
蛋白别名: (alpha-N-acetyl-neuraminyl-2,3-beta-galactosyl-1, 3)-N-acetylgalactosaminide alpha-2,6-sialyltransferase 6; Alpha-N-acetylgalactosaminide alpha-2,6-sialyltransferase 6; CMP-NeuAC:(beta)-N-acetylgalactosaminide (alpha)2,6-sialyltransferase member VI; epididymis secretory sperm binding protein; GalNAc alpha-2,6-sialyltransferase VI; Sialyltransferase 7F; sialytransferase 7 ((alpha-N-acetylneuraminyl 2,3-betagalactosyl-1,3)-N-acetyl galactosaminide alpha-2,6-sialytransferase) F; SIAT7-F; ST6 (alpha-N-acetyl-neuraminyl-2,3-beta-galactosyl-1,3)-N-acetylgalactosaminide alpha-2,6-sialyltransferase 6; ST6 (alpha-N-acetyl-neuraminyl-23-beta-galactosyl-13)-N- acetylgalactosaminide alpha-26-sialyltransferase 6 isoform ST6GALNAC6_1; ST6 (alpha-N-acetyl-neuraminyl-23-beta-galactosyl-13)-N- acetylgalactosaminide alpha-26-sialyltransferase 6 isoform ST6GALNAC6_2; ST6 -N-acetylgalactosaminide alpha-26-sialyltransferase 6; ST6 GalNAc alpha-2,6-sialyltransferase 6; ST6GalNAc VI; ST6GALNAC6; ST6GalNAcVI; unnamed protein product
基因别名: SIAT7-F; SIAT7F; ST6GALNAC6; ST6GALNACVI; UNQ708/PRO1359
UniProt ID: (Human) Q969X2, (Mouse) Q9JM95
Entrez Gene ID: (Human) 30815, (Mouse) 50935